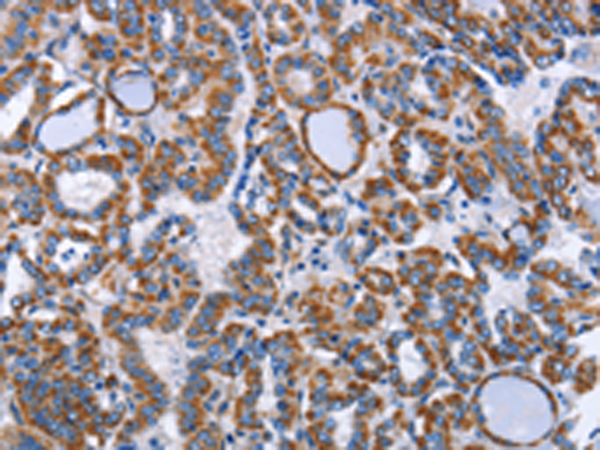
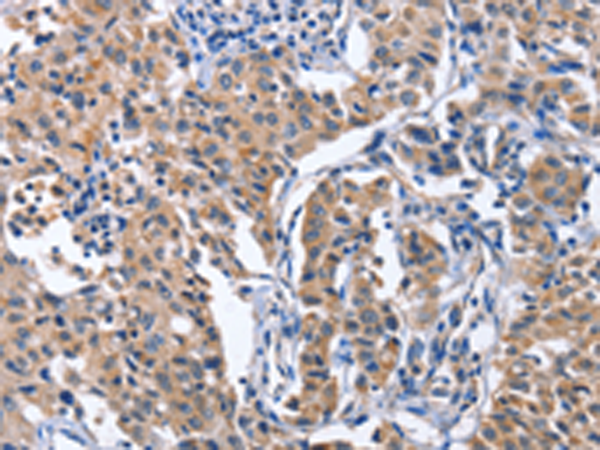

-
分类: 科研抗体货号: P07928别名: CD286应用: IHC反应种属: Human
-
分类: 科研抗体货号: P07907别名: PFM11应用: IHC反应种属: Human, Mouse
-
分类: 科研抗体货号: P07918别名: INT10; C8orf35应用: IHC反应种属: Human, Mouse
-
分类: 科研抗体货号: P07926别名: TIL3; SLEB1应用: IHC反应种属: Human
-
分类: 科研抗体货号: P07906别名: HYPB; SET2; HIF-1; HIP-1; KMT3A; HBP231; HSPC069; p231HBP应用: IHC反应种属: Human, Mouse
-
分类: 科研抗体货号: P07917别名: H-IDHG应用: WB,IHC反应种属: Human, Mouse, Rat
-
分类: 科研抗体货号: P07924别名: TIL4; CD282应用: WB,IHC反应种属: Human, Mouse
-
分类: 科研抗体货号: P07905别名: 1-8U; IP15; DSPA2b应用: WB,IHC反应种属: Human
-
分类: 科研抗体货号: P07916别名: RP46; H-IDHB应用: WB,IHC反应种属: Human, Mouse, Rat
-
分类: 科研抗体货号: P07921别名: Hdj1; Sis1; HSPF1; Hsp40; RSPH16B应用: WB,IHC反应种属: Human, Mouse

鄂公网安备42018502007531号
鄂公网安备42018502007531号

